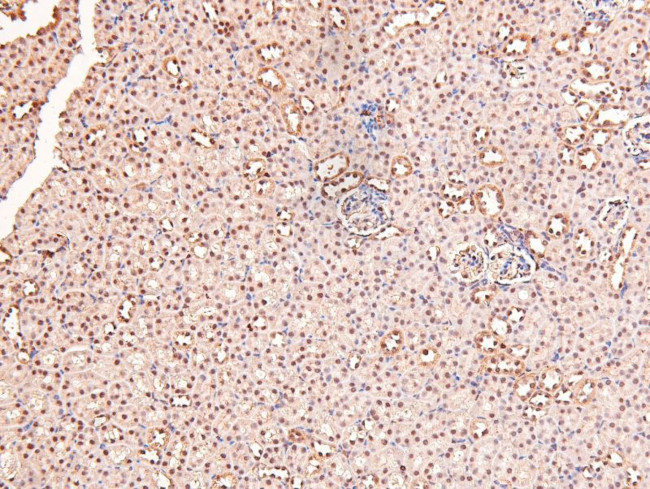
Phospho-RARA/RARB (Ser96) Antibody in Immunohistochemistry (Paraffin) (IHC (P))

Search
Invitrogen
Phospho-RARA/RARB (Ser96) Polyclonal Antibody
{{$productOrderCtrl.translations['antibody.pdp.commerceCard.promotion.promotions']}}
{{$productOrderCtrl.translations['antibody.pdp.commerceCard.promotion.viewpromo']}}
{{$productOrderCtrl.translations['antibody.pdp.commerceCard.promotion.promocode']}}: {{promo.promoCode}} {{promo.promoTitle}} {{promo.promoDescription}}. {{$productOrderCtrl.translations['antibody.pdp.commerceCard.promotion.learnmore']}}
图: 1 / 4
Phospho-RARA/RARB (Ser96) Antibody (PA5-105934) in IHC (P)




产品信息
PA5-105934
宿主/亚型
分类
类型
抗原
偶联物
形式
浓度
保存条件
运输条件
RRID
产品详细信息
Antibody detects endogenous levels of Retinoic Acid Receptor alpha/beta only when phosphorylated at Retinoic AcSer96.
靶标信息
Retinoic acid, a metabolite of vitamin A, is necessary for normal organogenesis but acts as a teratogen at high levels during embryonic and fetal development. Retinoic acid functions through its interaction with the nuclear protein, retinoic acid receptor (RAR). RAR belongs to the steroid and thyroid hormone superfamily of nuclear receptor proteins which exert their effects by binding to specific DNA response elements, thus regulating gene expression in target cells. RAR exists as three major subtypes: alpha, beta and gamma.
仅用于科研。不用于诊断过程。未经明确授权不得转售。